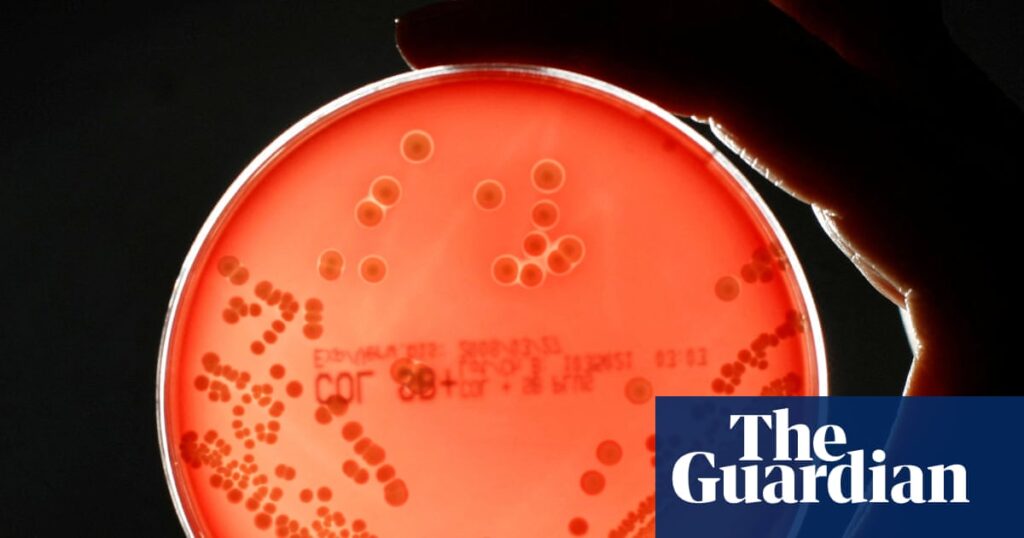
Superbugs could kill millions more and cost $2tn a year by 2050, models show | Antibiotics

970x125
Superbugs could cause millions more people to die worldwide and cost the global economy just under $2tn a year by 2050, modelling shows.A UK government-funded study shows that without concerted action, increased rates of antimicrobial resistance (AMR) could lead to global annual GDP losses of $1.7tn over the next quarter of a century.The research, by the Center for Global Development thinktank, found the US, UK and EU economies would be among the hardest hit, prompting accusations that recent swingeing aid cuts are self-defeating.On Thursday, the UK government announced it was axing funding for the Fleming fund, which combats AMR in low- and middle-income countries, as part of wider aid cuts. The Trump administration has confirmed $9bn in cuts to its foreign aid budget, while a number of European countries have also reduced spending on overseas aid.Anthony McDonnell, the lead author and the research and a policy fellow at the Center for Global Development, said: “When we conducted our research on the economic impacts of antimicrobial resistance, it was anticipated that resistance rates would continue to follow historical trends.“However, the sudden cuts to Official Development Assistance by the US, which has cut its aid spend by roughly 80%; the UK, which has announced aid cuts from 0.5% to 0.3% of gross national income; and substantial reductions by France, Germany, and others, could drive up resistance rates in line with the most pessimistic scenario in our research.“Even countries that have been successful in keeping AMR rates under control cannot afford to be complacent. Unless AMR programmes are protected from aid cuts, resistance rates across the world will likely increase at a rate in line with the worst-affected countries.“This would result in millions more people dying worldwide, including across G7 nations. Investing in treatment for bacterial infections now will save lives and deliver billions in long-term economic returns.”The research calculated the economic and health burden of antibiotic resistance for 122 countries and forecast that in that in this most pessimistic scenario, by 2050, GDP losses in China could reach just under $722bn a year, the US $295.7bn, the EU $187bn, Japan $65.7bn and the UK $58.6bn.According to the Institute for Health Metrics and Evaluation (IHME), deaths from AMR are expected to increase 60% by 2050, with 1.34 million people in the US and 184,000 in the UK alone predicted to die each year from antibiotic resistant bugs, while numbers of those becoming seriously ill from drug-resistant bacteria are also expected to jump.Superbugs increase the number of hospital admissions and lead to longer and more intensive hospital stays, costlier second-line treatments and more complex care, meaning resistant infections are roughly twice as expensive to treat as those for which antibiotics are effective.The study estimates global health costs of treating AMR could increase by just under $176bn a year, while in the UK, they would rise from $900m to $3.7bn and in the US from $15.5bn to just under $57bn.Higher rates of resistant bugs would also shrink the UK, EU and US workforces by 0.8%, 0.6% and 0.4% respectively, the study found.But if countries invest more in tackling superbugs – increasing access to new antibiotics and high-quality treatment of these infections – the US economy would grow $156.2bn a year and the UK $12bn (£9.3bn) by 2050.Responding to the findings, Dr Mohsen Naghavi, a professor of health metrics at IHME, said: “Today the threat of AMR is increasing, and without immediate action from all stakeholders the medicines we have access to now could stop working, potentially causing a simple infection to become deadly.”That would involve policy changes from the US, European and UK governments, the development of new drugs and ensuring everyone understood that antibiotics were ineffective against viruses, he added.A UK government spokesperson said: “Our 10-year health plan recognises antimicrobial resistance (AMR) as a major threat and commits to urgently tackle its spread, including through new vaccines.“We have made important progress – reducing antibiotic use in meat and pioneering a world-first subscription model to incentivise the development of new treatments. We also continue to work closely with international partners to influence global efforts to limit the spread of AMR.”
970x125
970x125